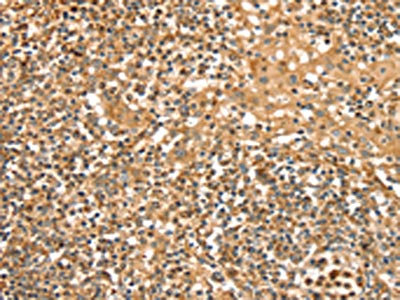

SLC8A3 Antibody
-
中文名稱:SLC8A3兔多克隆抗體
-
貨號:CSB-PA966001
-
規格:¥1100
-
圖片:
-
The image on the left is immunohistochemistry of paraffin-embedded Human tonsil tissue using CSB-PA966001(SLC8A3 Antibody) at dilution 1/35, on the right is treated with synthetic peptide. (Original magnification: ×200)
-
The image on the left is immunohistochemistry of paraffin-embedded Human cervical cancer tissue using CSB-PA966001(SLC8A3 Antibody) at dilution 1/35, on the right is treated with synthetic peptide. (Original magnification: ×200)
-
-
其他:
產品詳情
-
Uniprot No.:
-
基因名:
-
別名:SLC8A3 antibody; NCX3 antibody; Sodium/calcium exchanger 3 antibody; Na(+)/Ca(2+)-exchange protein 3 antibody; Solute carrier family 8 member 3 antibody
-
宿主:Rabbit
-
反應種屬:Human,Rat
-
免疫原:Synthetic peptide of Human SLC8A3
-
免疫原種屬:Homo sapiens (Human)
-
標記方式:Non-conjugated
-
抗體亞型:IgG
-
純化方式:Antigen affinity purification
-
濃度:It differs from different batches. Please contact us to confirm it.
-
保存緩沖液:-20°C, pH7.4 PBS, 0.05% NaN3, 40% Glycerol
-
產品提供形式:Liquid
-
應用范圍:ELISA,IHC
-
推薦稀釋比:
Application Recommended Dilution ELISA 1:1000-1:2000 IHC 1:25-1:100 -
Protocols:
-
儲存條件:Upon receipt, store at -20°C or -80°C. Avoid repeated freeze.
-
貨期:Basically, we can dispatch the products out in 1-3 working days after receiving your orders. Delivery time maybe differs from different purchasing way or location, please kindly consult your local distributors for specific delivery time.
-
用途:For Research Use Only. Not for use in diagnostic or therapeutic procedures.
相關產品
靶點詳情
-
功能:Mediates the electrogenic exchange of Ca(2+) against Na(+) ions across the cell membrane, and thereby contributes to the regulation of cytoplasmic Ca(2+) levels and Ca(2+)-dependent cellular processes. Contributes to cellular Ca(2+) homeostasis in excitable cells, both in muscle and in brain. In a first phase, voltage-gated channels mediate the rapid increase of cytoplasmic Ca(2+) levels due to release of Ca(2+) stores from the endoplasmic reticulum. SLC8A3 mediates the export of Ca(2+) from the cell during the next phase, so that cytoplasmic Ca(2+) levels rapidly return to baseline. Contributes to Ca(2+) transport during excitation-contraction coupling in muscle. In neurons, contributes to the rapid decrease of cytoplasmic Ca(2+) levels back to baseline after neuronal activation, and thereby contributes to modulate synaptic plasticity, learning and memory. Required for normal oligodendrocyte differentiation and for normal myelination. Mediates Ca(2+) efflux from mitochondria and contributes to mitochondrial Ca(2+) ion homeostasis.
-
基因功能參考文獻:
- These results...suggest that cells can use a dynamic Ca(2+) signaling toolkit in which the NCX3 sub-cellular localization changes in synchrony with the cell cycle PMID: 29526322
- stimulation of NCX3 by PKA occurred through residue S524. This effect may well participate in the fight-or-flight response in skeletal muscle and the long-term potentiation in hippocampus. PMID: 28233567
- In the discovery phase, 60 loci not previously associated with rheumatoid arthritis risk showed evidence for association and were tested for replication in the validation cohort. A total of 12 loci were replicated at the nominal level. When combining the discovery and validation cohorts, an intronic SNP in SLC8A3 was found to be associated with ACPA-positive rheumatoid arthritis at a genome-wide level of significance. PMID: 26983453
- Ayloid beta mediates calpain cleavage of NCX3 in Alzheimer's disease brain. PMID: 23919677
- calcium signaling mediated by NCX3 has a crucial role in oligodendrocyte maturation and myelin formation. PMID: 21959935
- The gene promoter of the human isoform of this protein is controlled by cAMP and calcium. PMID: 12502570
- This review examines the regulatory features and expression pattern of the SLC8A3 gene which suggest that NCX3 activity could be crucial in neuronal functions such as memory formation and sensory processing. PMID: 15247490
- Studies show that both alternatively spliced variants can be translated into protein. PMID: 15777725
- The downregulation of the regulator of Ca2+ homeostasis NCX3 by Ca2+-regulated DREAM is a striking example of the autoregulatory property of the Ca2+ signal in neurons. PMID: 16306395
顯示更多
收起更多
-
亞細胞定位:Cell membrane; Multi-pass membrane protein. Perikaryon. Cell projection, dendrite. Cell projection, dendritic spine. Cell membrane, sarcolemma. Cytoplasm, sarcoplasm. Cell junction. Mitochondrion outer membrane; Multi-pass membrane protein. Cytoplasm, perinuclear region. Endoplasmic reticulum membrane; Multi-pass membrane protein.
-
蛋白家族:Ca(2+):cation antiporter (CaCA) (TC 2.A.19) family, SLC8 subfamily
-
組織特異性:Isoform 2 is expressed in brain and skeletal muscle. Isoform 3 is expressed in excitable cells of brain, retina and skeletal muscle. Isoform 4 is expressed in skeletal muscle.
-
數據庫鏈接:
Most popular with customers
-
-
YWHAB Recombinant Monoclonal Antibody
Applications: ELISA, WB, IHC, IF, FC
Species Reactivity: Human, Mouse, Rat
-
Phospho-YAP1 (S127) Recombinant Monoclonal Antibody
Applications: ELISA, WB, IHC
Species Reactivity: Human
-
-
-
-
-